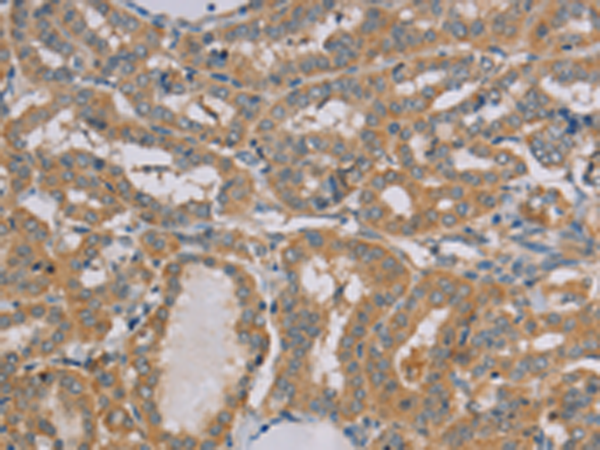
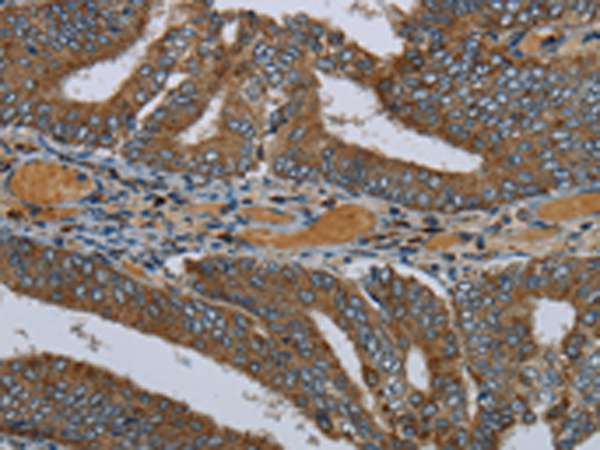

-
分类: 科研抗体货号: P08519别名: L11MT; CGI-113; MRP-L11应用: WB,IHC反应种属: Human, Mouse, Rat
-
分类: 科研抗体货号: P08520别名: KLIP1; PBIP1; CENP50; MLF1IP; CENPU50应用: IHC反应种属: Human
-
分类: 科研抗体货号: P08535别名: CMH8; VLC1; MLC1V; MLC1SB应用: WB,IHC反应种属: Human, Mouse, Rat
-
分类: 科研抗体货号: P08518别名: Mi-er2; KIAA1193应用: IHC反应种属: Human, Mouse
-
分类: 科研抗体货号: P08534别名: MK; LRBP; MVLK; POROK3应用: WB,IHC反应种属: Human, Mouse, Rat
-
分类: 科研抗体货号: P08517别名: DERP2; MICS1; My021; PTD010; TMBIM5; HSPC282应用: IHC反应种属: Human, Mouse, Rat
-
分类: 科研抗体货号: P08533别名: ATBP; ATIP; ICIS; MP44; MTSG1应用: IHC反应种属: Human, Mouse, Rat
-
分类: 科研抗体货号: P08516别名: PEPCK; PEPCK2; PEPCK-M应用: WB,IHC反应种属: Human, Mouse
-
分类: 科研抗体货号: P08532别名: MTP18; HSPC242应用: WB,IHC反应种属: Human, Mouse
-
分类: 科研抗体货号: P08542别名: G6; NCC27应用: WB,IHC反应种属: Human, Mouse, Rat

鄂公网安备42018502007531号
鄂公网安备42018502007531号

